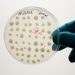
SolasCure Ltd. wird Medizinprodukte vermarkten, die auf dem neuen von der Brain AG entwickelten enzymatischen Wirkstoff Aurase beruhen.

Gemeinsam mit Shell hat Yokogawa die Software-Suite „Platform for Advanced Control and Estimation R5.02“ entwickelt und im Juli 2018 auf den Markt gebracht.
Die Plattform für erweiterte Regelungs- und Prognosetechnologie kombiniert die von Shell entwickelte Prozessregelung mit der von Yokogawa entwickelten Echtzeit-Automatisierungstechnologie. Das Upgrade R5.02 bietet erweiterte Funktionen, die den Kunden helfen, eine hohe Systemverfügbarkeit aufrechtzuerhalten, die Arbeitsbelastung der Bediener zu reduzieren und die Produktivität zu steigern. Die Software-Suite gehört zu Yokogawas Produktfamilie OpreX Asset Operations and Optimisation.
Die „Platform for Advanced Control and Estimation“ bietet die folgenden Funktionen:
- multivariable modell-prädiktive Regelung: eine Funktion zur Modellierung der dynamischen Eigenschaften von Anlagenreaktionen und Steuerung multipler Variablen basierend auf Modellprognosen
- Softsensorik: eine Funktion zur Qualitätsbewertung in Echtzeit, basierend auf Temperatur, Durchfluss, Druck und anderen Prozesswerten
- verschiedene Berechnungsfunktionen
Verbesserungen
- Anlagenweite Optimierung der Prozessregelung bei Großanwendungen
Bei großformatigen Anwendungen müssen moderne Prozessleitsysteme in der Lage sein, große Datenmengen schnell zu verarbeiten. Version 5.01 dieser Software-Suite eignet sich für kleine bis mittlere Anwendungen und kann die Regelung einzelner Prozesse optimieren. Mit dem Upgrade R5.02 bietet die Software-Suite eine deutlich höhere Verarbeitungsgeschwindigkeit und kann auch große Anwendungen mit mehreren Prozessen bewältigen.
Bisher mussten die Bediener das Prozessleitsystem und die Advanced-Process-Control-Lösungen auf getrennten Bildschirmen beobachten und bedienen. Bei R5.02 sind jetzt alle Daten und Informationen beider Systeme auf einem Bildschirm integriert angezeigt. Durch den Zugriff auf alle diese Daten an einem Ort können sie deutlich schneller auf Änderungen reagieren.
- Sicherstellen einer hohen Anlagenverfügbarkeit – unabhängig von Änderungen der Betriebsbedingungen oder Alterung der Anlagen
Mit dieser Software kann eine Trendlinie, die die vorhergesagten Werte bei Aktivierung der erweiterten Steuerung (Closed-Loop-Prediction-Trend) anzeigt, über eine Trendlinie gelegt werden, die auf den aktuellen Messwerten basiert. Durch diesen Vergleich können Fehler in einem dynamischen Reaktionsmodell leicht identifiziert werden. Solche Fehler entstehen durch geänderte Betriebsbedingungen oder die Alterung von Anlagen. Die Systemverfügbarkeit kann sichergestellt werden, indem das dynamische Reaktionsmodell neu aufgebaut wird, wenn diese Fehler signifikant werden.
R5.02 wurde erweitert, um die Anzeige einer Trendlinie zu ermöglichen, die das Verhalten der Anlage vorhersagt, wenn die erweiterte Steuerung inaktiv ist (Open-Loop-Trend). So wissen die Bediener im Voraus, welche Auswirkungen dies auf einen Prozess haben wird.
- Verbesserte Bedienbarkeit für effiziente Anlagenabläufe und eine effektive Überwachung
Mit nur einem einzigen Tastendruck kann der Bediener Elemente aus einer Liste der zuletzt angezeigten Bildschirme aufrufen. Häufig genutzte Bildschirme können auch schnell aufgerufen werden, indem man sie als Favoriten registriert.
Hochentwickelte Prozessleitsysteme erhöhen die Produktausbeute und senken den Energieverbrauch, indem sie dafür sorgen, dass sich Temperatur, Durchfluss, Druck und andere Prozesswerte in einem festgelegten Bereich bewegen und möglichst ihren optimalen Sollwerten entsprechen. Diese Systeme werden zunehmend in Anlagen wie Ölraffinerien, petrochemischen Anlagen, Chemieanlagen und Erdgasverflüssigungsanlagen eingesetzt. Advanced-Process-Control-Lösungen stoßen weltweit auf großes Interesse, da sie die Steigerung der Produktivität ermöglichen.